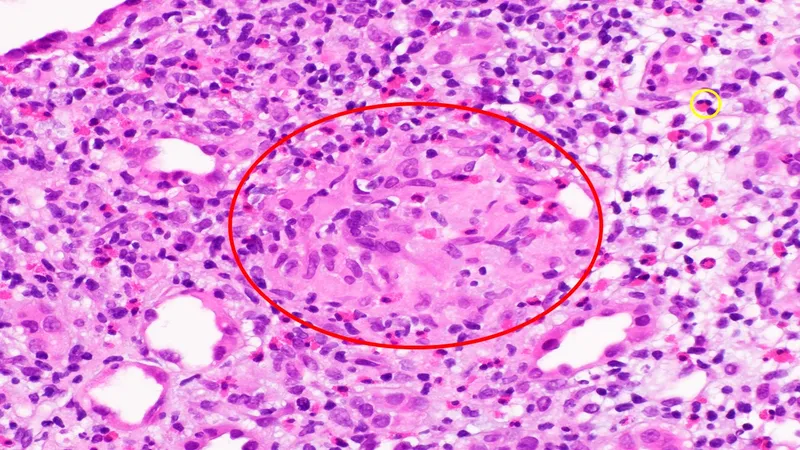
Kidney biopsy showing granulomatous interstitial nephritis

TID 101 - Tubule Trouble Territory
- Definition: Diseases primarily impacting renal tubules & interstitium.
- Key Feature: Glomeruli & vasculature initially spared.
- Classification:
- Acute Tubulointerstitial Nephritis (ATIN): Rapid onset, often drug-induced.
- Chronic Tubulointerstitial Nephritis (CTIN): Gradual, progressive fibrosis.
- Common Etiologies: Drugs (e.g., NSAIDs, PPIs, antibiotics), infections, toxins, systemic diseases (e.g., sarcoidosis, Sjögren's).
⭐ Tubulointerstitial diseases primarily affect the renal tubules and interstitium, sparing the glomeruli and vasculature initially.
Acute TIN - Sudden Strike Nephritis
Inflammation of renal tubules & interstitium; rapid kidney dysfunction.
- Etiology:
- Drugs (~70%): Penicillins, NSAIDs, PPIs, sulfonamides. (📌 "P" drugs: Penicillins, PPIs, Painkillers (NSAIDs), Pee pills (diuretics))
- Infections: Bacterial (pyelonephritis), viral.
- Systemic: Sarcoidosis, SLE, TINU.
⭐ Drug-induced hypersensitivity (e.g., penicillins, NSAIDs, PPIs) is the most common cause of Acute Tubulointerstitial Nephritis (ATIN).
-
Clinical Features:
- Triad (10-15%): Fever, rash, arthralgia.
- AKI: ↑Cr, oliguria.
- Urine: Eosinophiluria (Hansel/Wright), sterile pyuria, WBC casts, proteinuria (<1g/d).
-
Diagnosis:
- Clinical suspicion + UA.
- Renal biopsy (gold standard): Interstitial edema, inflammatory infiltrates (eosinophils).

-
Management:
- Corticosteroids (Prednisolone **1**mg/kg/d) if severe/persistent post drug withdrawal.
Chronic TIN - The Silent Scarring
Insidious, progressive interstitial fibrosis & tubular atrophy, leading to CKD.
- Key Causes:
- Drugs: Analgesics (phenacetin, NSAIDs), lithium, cyclosporine, aristolochic acid.
- Heavy Metals: Lead, cadmium.
- Metabolic: Chronic hypokalemia/hypercalcemia, hyperuricemia, oxalate nephropathy.
- Immunologic: Sjögren's, sarcoidosis, IgG4-RD.
- Infections: Chronic pyelonephritis (reflux nephropathy).
- Hereditary: Medullary cystic kidney disease.
- Features:
- Often asymptomatic; gradual onset.
- Polyuria, nocturia (impaired concentration).
- Sterile pyuria, mild proteinuria (< 1 g/day).
- Hypertension, progressive ↓ GFR.
- Diagnosis:
- Biopsy: Interstitial fibrosis, tubular atrophy.
- Imaging: Small, scarred kidneys; papillary calcification (analgesics).
- Outcome: CKD, ESRD, papillary necrosis.
⭐ Analgesic nephropathy, classically associated with phenacetin-containing compounds, is a prototype of drug-induced Chronic Tubulointerstitial Nephritis and a major cause of renal papillary necrosis.
Spotlight Syndromes - TID's Notorious Names
- Analgesic Nephropathy
- Cause: Chronic high-dose NSAIDs, paracetamol; (phenacetin historically).
- Patho: Papillary necrosis, chronic interstitial nephritis.
- Clinical: Sterile pyuria, hematuria, proteinuria, renal insufficiency.
- Complication: ↑ risk of urothelial carcinoma.
⭐ Sterile pyuria and microscopic hematuria are characteristic findings in analgesic nephropathy.

- Reflux Nephropathy
- Cause: Chronic vesicoureteral reflux (VUR) ± recurrent UTIs.
- Patho: Focal/segmental glomerulosclerosis (FSGS) on background of scarring.
- Clinical: Polar renal scars (esp. upper/lower poles), HTN, proteinuria. Often childhood.
- Urate Nephropathy (Gouty Nephropathy)
- Acute: Uric acid crystal deposition in tubules (e.g., tumor lysis syndrome).
- Chronic: Monosodium urate (MSU) crystal deposition in interstitium (chronic gout).
- Clinical: Gout, tophi, urate stones, HTN, progressive CKD.
- Lead Nephropathy (Saturnine Gout)
- Cause: Chronic lead exposure.
- Clinical: Interstitial fibrosis, hyperuricemia, gout, HTN, slow CKD progression.
High‑Yield Points - ⚡ Biggest Takeaways
- Acute Interstitial Nephritis (AIN): Often drug-induced; classic triad fever, rash, eosinophilia. Eosinophiluria is a key finding.
- Analgesic Nephropathy: Chronic NSAID/analgesic use causes papillary necrosis.
- Chronic Interstitial Nephritis: Characterized by tubular atrophy and interstitial fibrosis.
- Renal Tubular Acidosis: Type 1 RTA (distal): hypokalemia, nephrocalcinosis. Type 4 RTA: hyperkalemia.
- Fanconi Syndrome: Generalized proximal tubular defect: phosphaturia, glucosuria, aminoaciduria.
- Myeloma Kidney: Light chain cast nephropathy causing tubular obstruction and inflammation.
Unlock the full lesson and continue reading
Signup to continue reading this lesson and unlimited access questions, flashcards, AI notes, and more